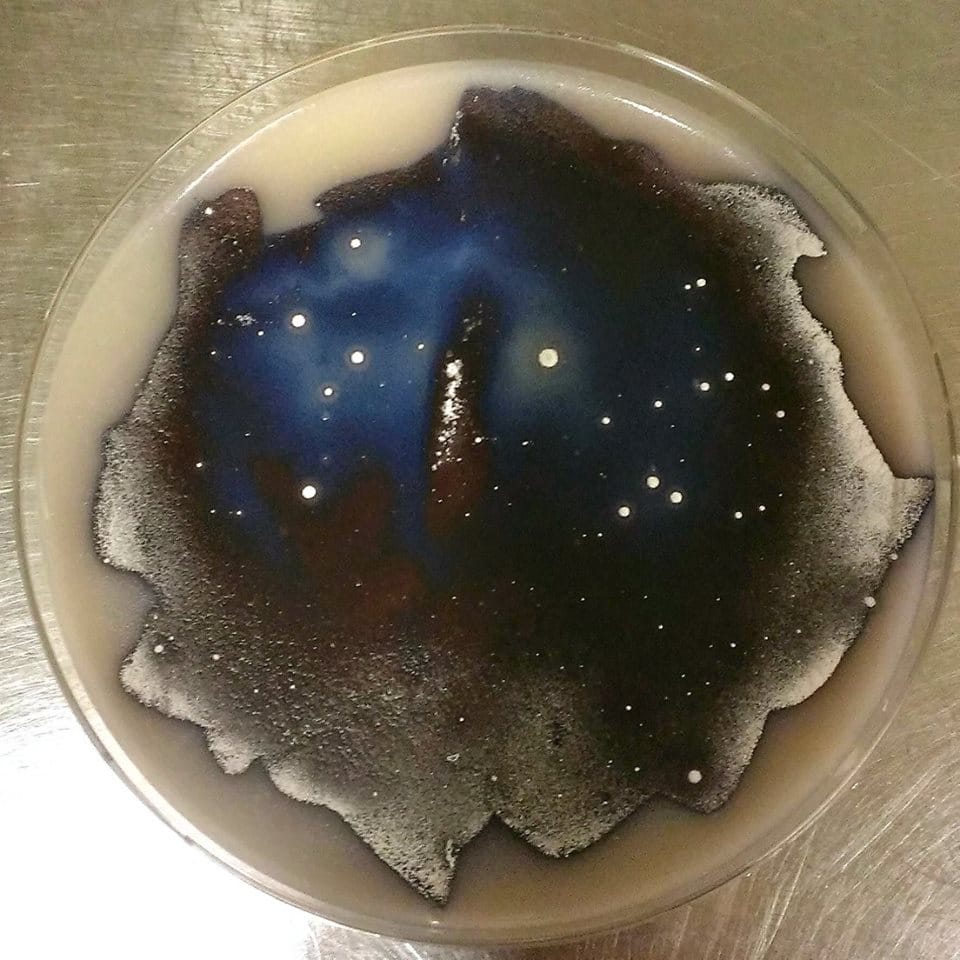
The Streptomyces Sky

Art Grown in a Petri Dish
A microbe-filled petri dish isn't usually where one would expect to find art, but it turns out that cell colonies can form some pretty compelling visuals.

A microbe-filled petri dish isn’t usually where one would expect to find art, but it turns out that cell colonies can form some pretty compelling visuals. We’ve already seen the potential of slime mold and the bacteria from Hans Ulrich Obrist’s nose, so it’s only natural that the medium is growing (in more ways than one): this year, the American Society for Microbiology (ASM) launched its first Agar Art contest, inviting ASM members to get creative and paint with microorganisms within the framework of a petri dish. The society announced its winners last week, but we had some fun poking through the many submissions, which do show that yes, bacteria can be beautiful.
The honor of first place went to “Neurons,” a vivid work of yellow and orange bacteria by molecular biologist Mehmet Berkmen and mixed media artist Maria Penil, who integrates biological shapes into her own work. “NYC Biome MAP,” a glowing, grided representation of Manhattan, was runner-up, submitted by nonprofit community biolab Genspace. Created as part of this past IDEAS CITY Festival hosted by the New Museum, it is a crowdsourced work composed of multiple petri dishes, each prepared with stencils of city grids. Participants painted these with genetically engineered bacteria, modified with fluorescent protein so that they form a dazzling map under UV light.
Other standouts include a detailed portrait of French chemist and microbiologist Louis Pasteur rendered with a dark violet bacterium, a cosmic colony that resembles a piece of the night sky, and a five-dish homage to van Gogh’s “Starry Night” that recreates the painting’s famous swirls out of infection-causing bacteria.
Images of the petri dishes will be on view this fall at an Agar Art Gallery event hosted by Microbes After Hours. We knew there was another reason why they’re also called culture dishes.